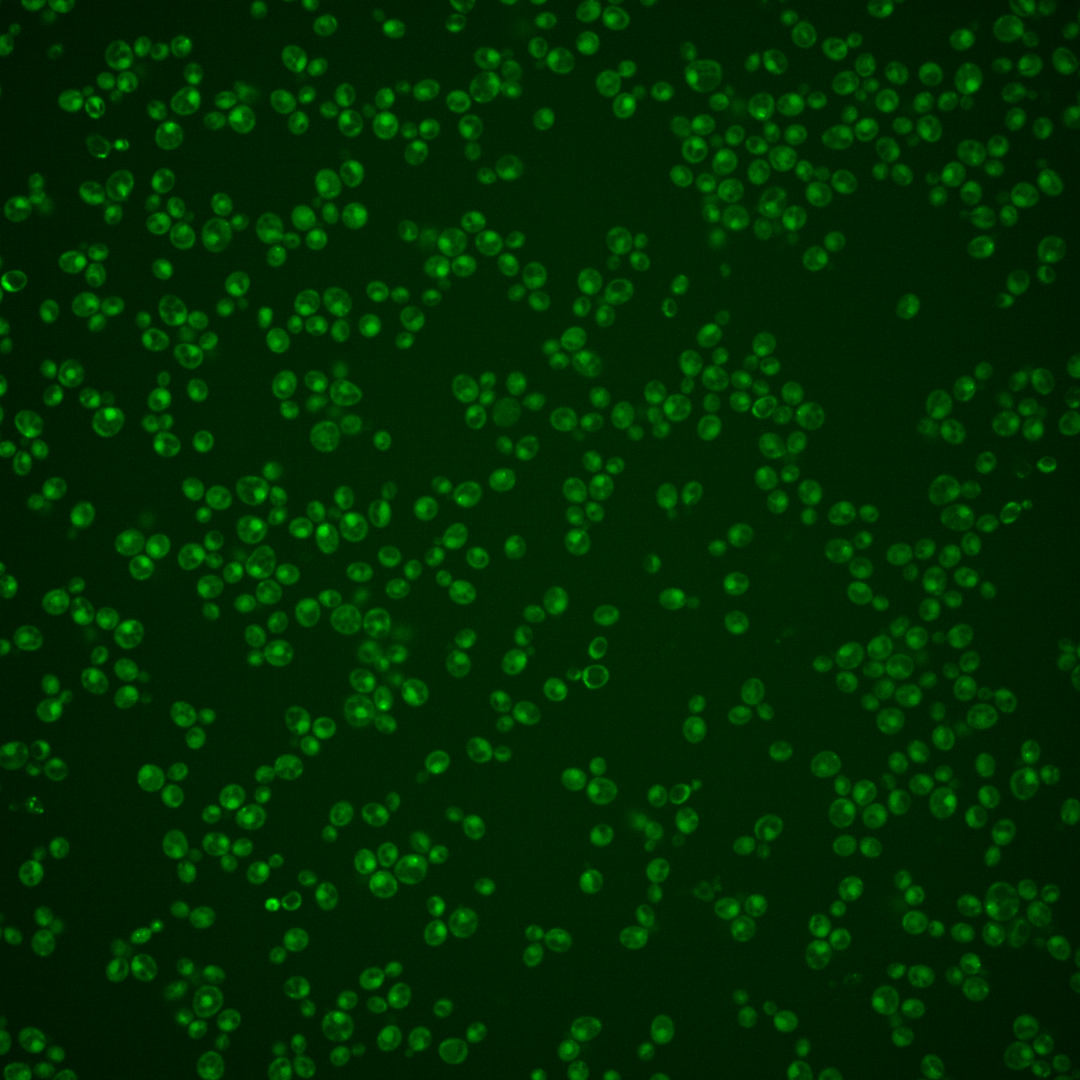
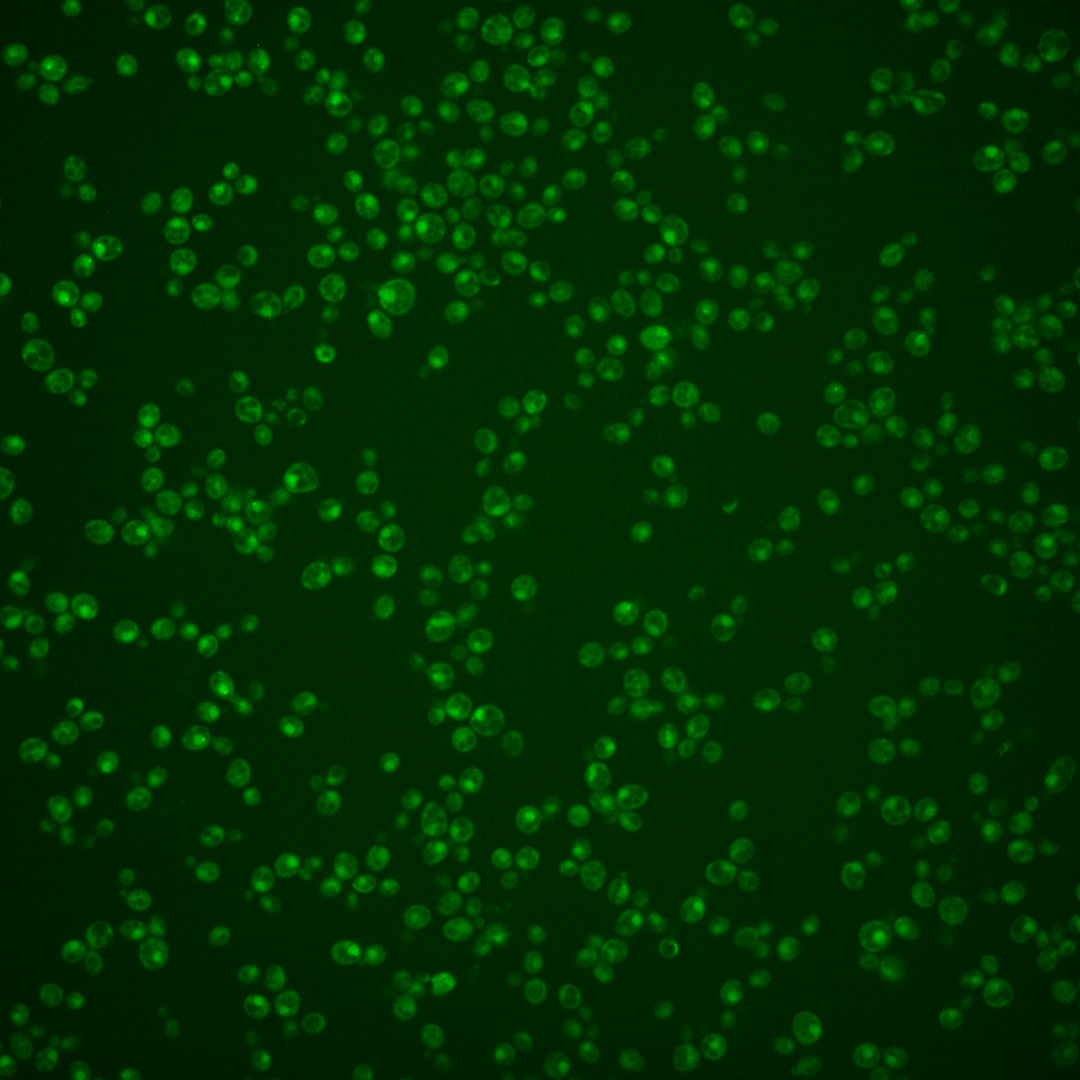
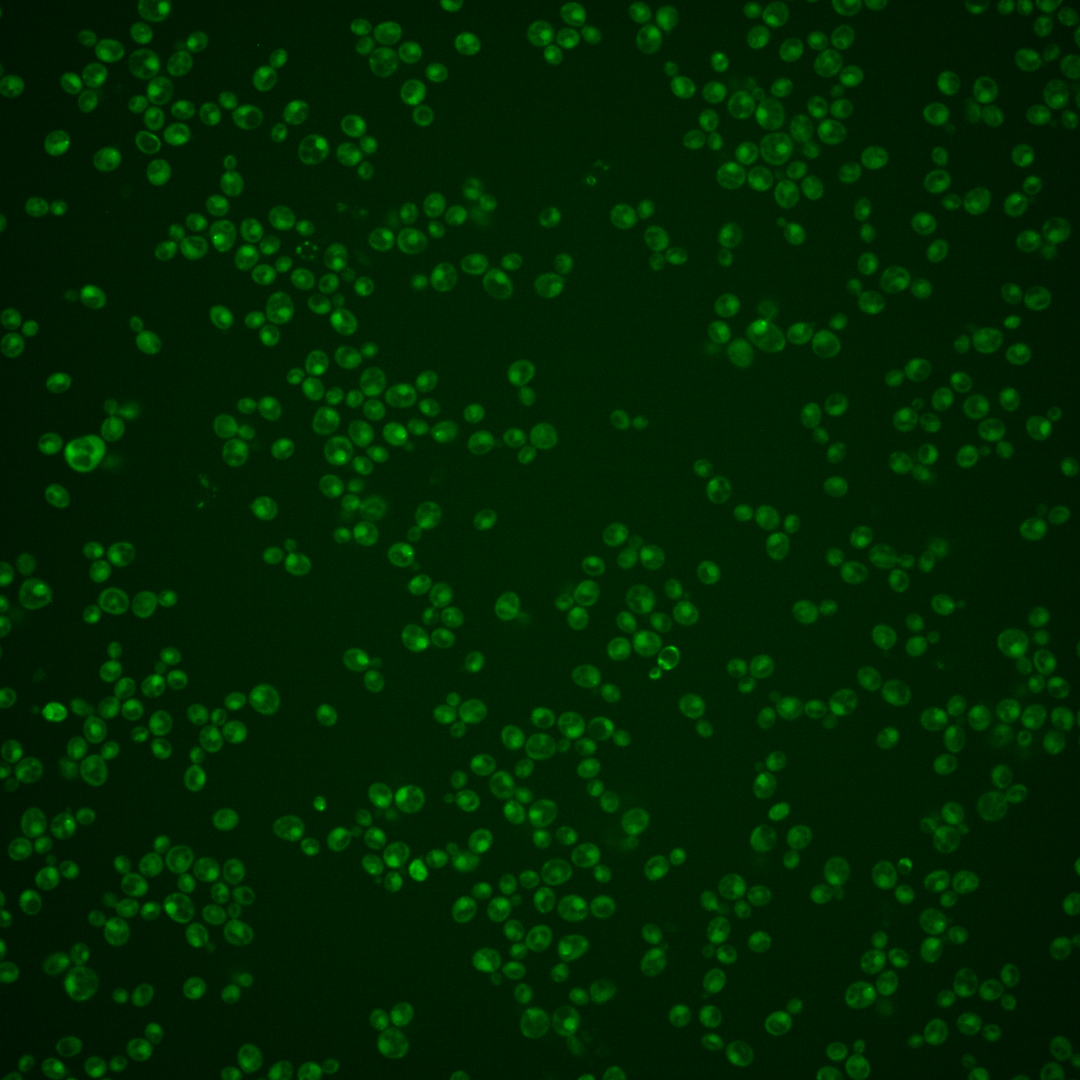
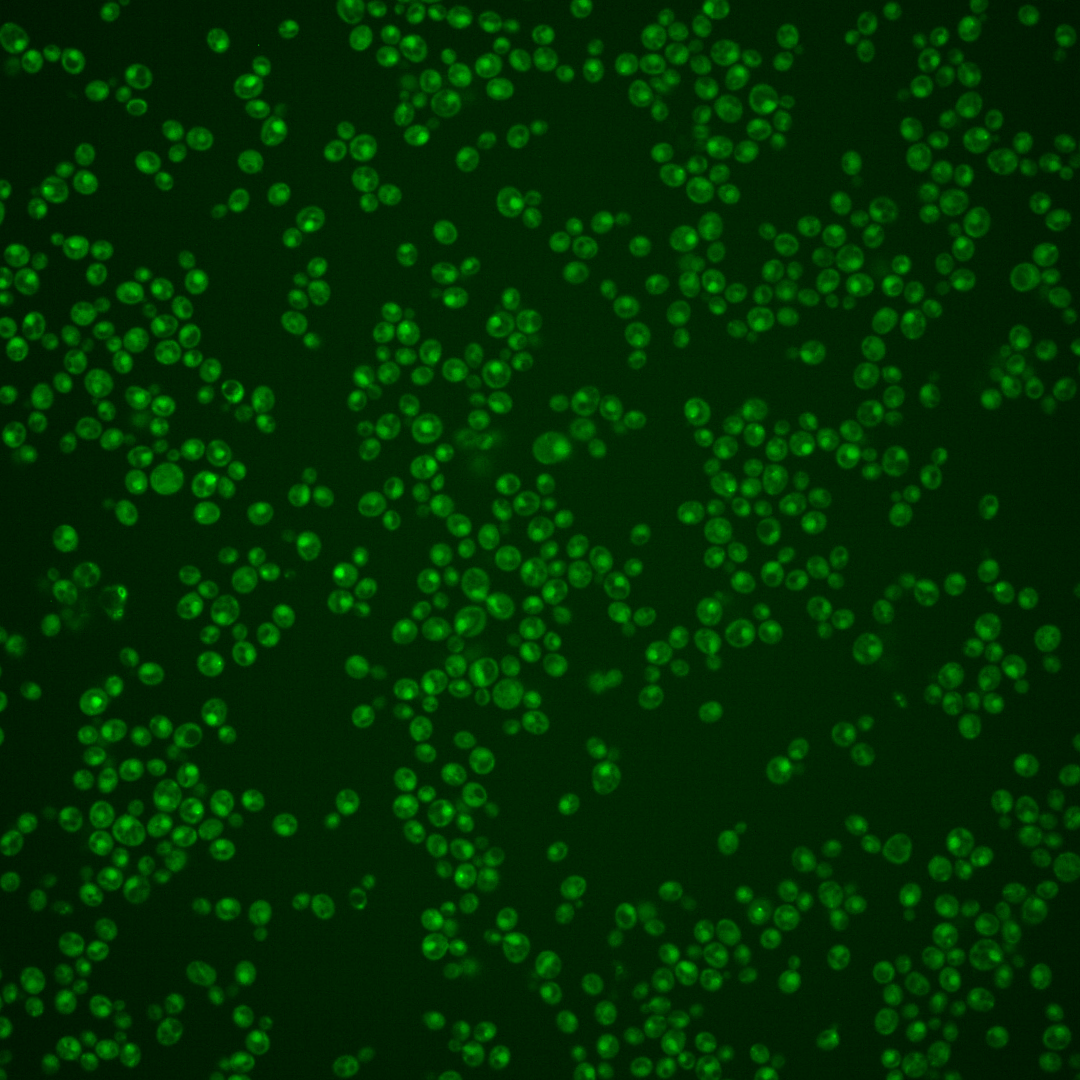
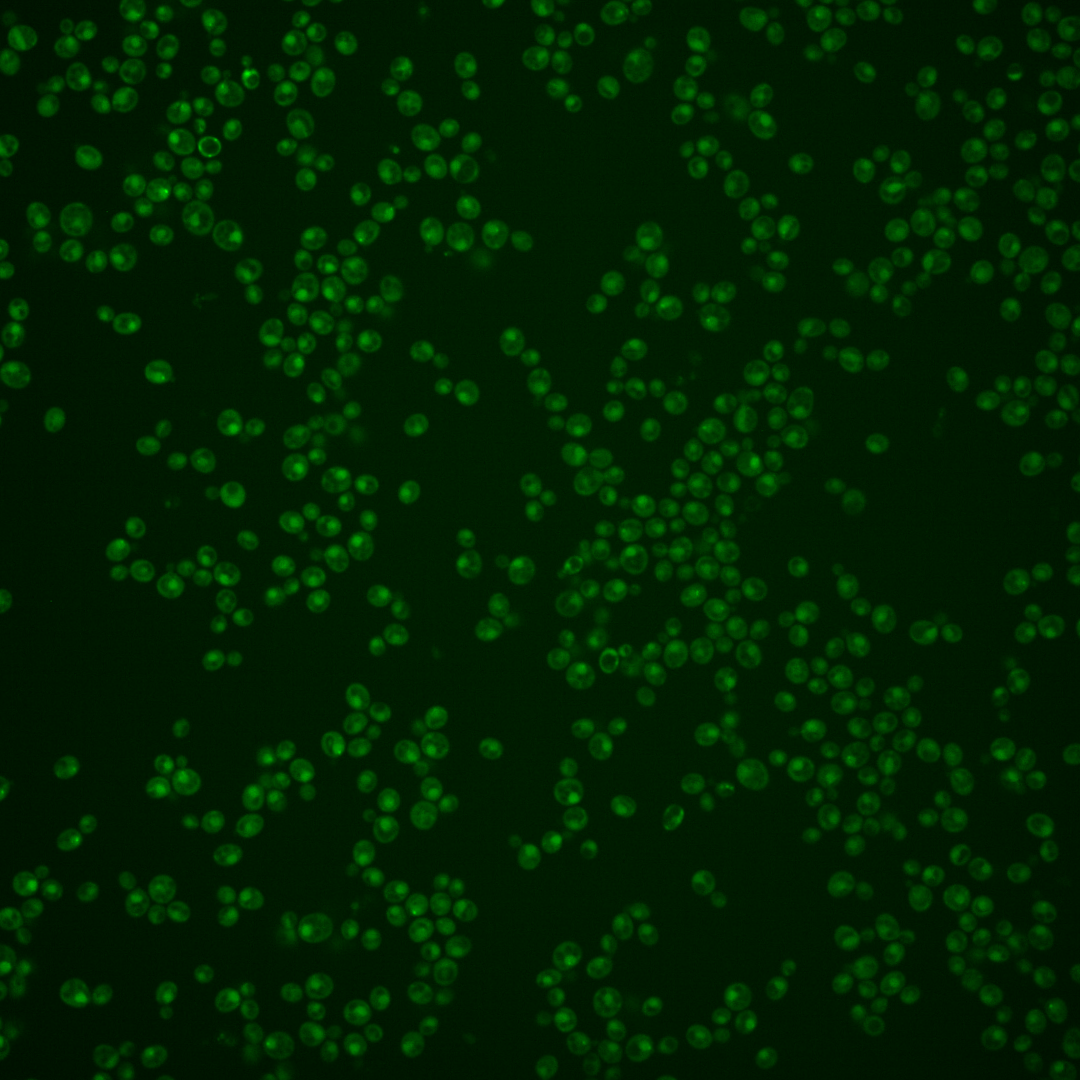
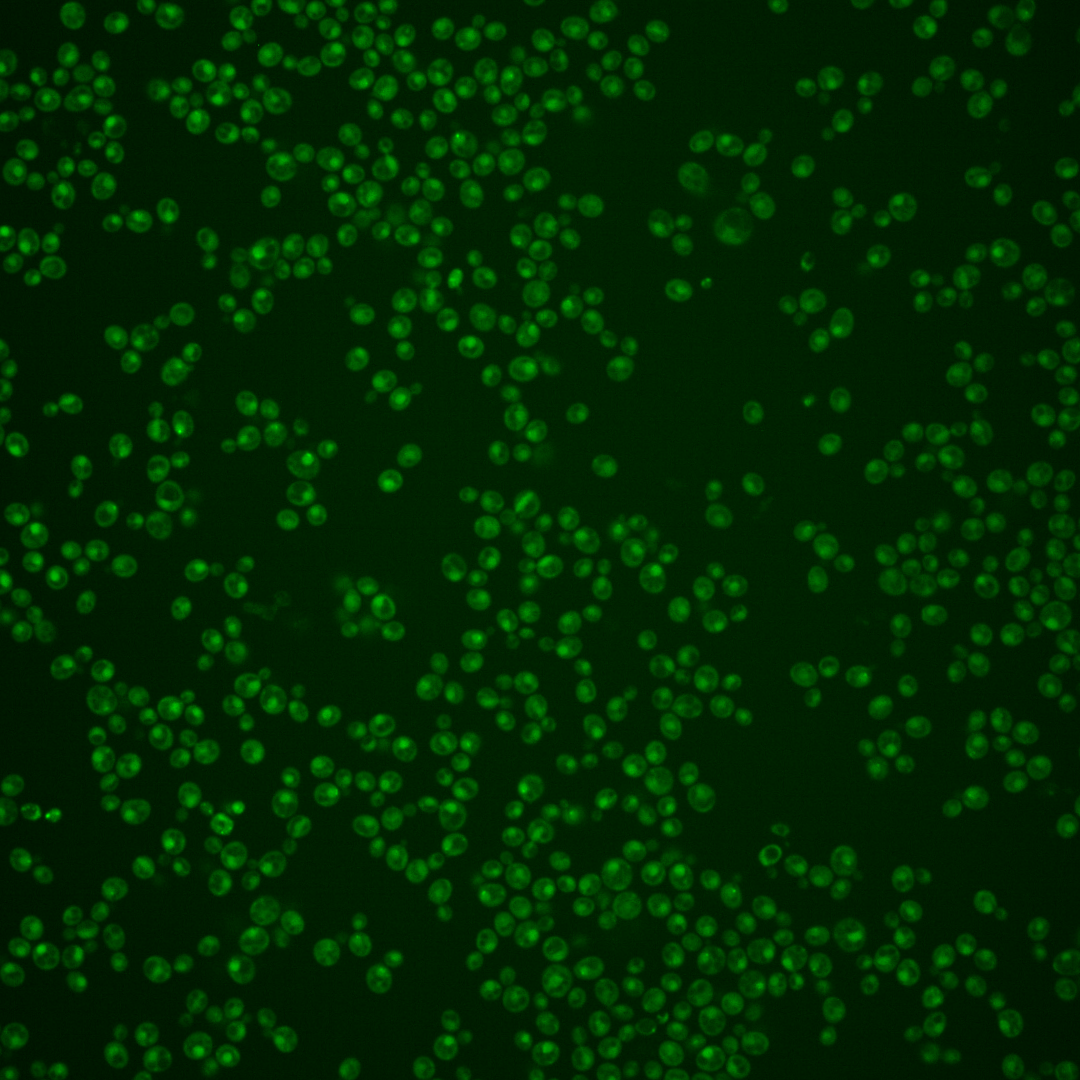

| Standard name | |
|---|---|
| Human Ortholog | |
| Description | Kinetochore checkpoint WD40 repeat protein; localizes to kinetochores during prophase and metaphase, delays anaphase in the presence of unattached kinetochores; forms complexes with Mad1p-Bub1p and with Cdc20p, binds Mad2p and Mad3p; functions at kinetochore to activate APC/C-Cdc20p for normal mitotic progression |
Micrographs




















































































Sub-cellular Localization
Yeast GFP Assignment
Protein Abundance
Localization Change
External localization resources
| ensLOC | DeepLoc | |||||||||||||||||||||||
|---|---|---|---|---|---|---|---|---|---|---|---|---|---|---|---|---|---|---|---|---|---|---|---|---|
| Localization | WT1 | WT2 | WT3 | RAP60 | RAP140 | RAP220 | RAP300 | RAP380 | RAP460 | RAP540 | RAP620 | RAP700 | HU80 | HU120 | HU160 | rpd3Δ_1 | rpd3Δ_2 | rpd3Δ_3 | WT1 | WT2 | WT3 | AF100 | AF140 | AF180 |
| Cortical Patches | 0 | 0 | 0 | 0 | 0 | 0 | 0 | 1 | 0 | 0 | 0 | 0 | 1 | 0 | 0 | 0 | 0 | 0 | 0 | 0 | 0 | 1 | 1 | 4 |
| Bud | 0 | 0 | 0 | 0 | 0 | 0 | 4 | 3 | 4 | 2 | 8 | 6 | 0 | 0 | 0 | 0 | 0 | 0 | 2 | 4 | 1 | 4 | 13 | 9 |
| Bud Neck | 0 | 0 | 3 | 2 | 8 | 1 | 4 | 8 | 2 | 1 | 0 | 3 | 5 | 8 | 5 | 0 | 0 | 0 | 0 | 1 | 0 | 1 | 9 | 13 |
| Bud Site | 0 | 0 | 0 | 0 | 0 | 2 | 5 | 8 | 4 | 6 | 7 | 6 | 0 | 0 | 0 | 0 | 0 | 1 | – | – | – | – | – | – |
| Cell Periphery | 0 | 0 | 0 | 0 | 0 | 0 | 0 | 0 | 0 | 0 | 0 | 0 | 3 | 0 | 1 | 0 | 0 | 0 | 0 | 0 | 0 | 0 | 0 | 0 |
| Cytoplasm | 41 | 32 | 42 | 46 | 68 | 84 | 95 | 118 | 64 | 79 | 70 | 73 | 116 | 180 | 234 | 27 | 34 | 24 | 38 | 17 | 24 | 59 | 118 | 123 |
| Endoplasmic Reticulum | 2 | 0 | 1 | 0 | 2 | 1 | 1 | 0 | 1 | 0 | 0 | 1 | 0 | 3 | 2 | 10 | 5 | 9 | 0 | 0 | 0 | 0 | 2 | 3 |
| Endosome | 3 | 7 | 3 | 6 | 7 | 4 | 0 | 2 | 2 | 2 | 0 | 1 | 7 | 32 | 32 | 12 | 16 | 21 | 3 | 4 | 1 | 1 | 5 | 6 |
| Golgi | 0 | 0 | 0 | 0 | 0 | 0 | 0 | 0 | 1 | 0 | 0 | 0 | 1 | 1 | 2 | 1 | 0 | 1 | 0 | 1 | 0 | 0 | 1 | 1 |
| Mitochondria | 71 | 4 | 3 | 10 | 19 | 92 | 156 | 155 | 144 | 124 | 227 | 130 | 9 | 0 | 3 | 12 | 5 | 8 | 9 | 5 | 9 | 11 | 27 | 20 |
| Nucleus | 51 | 73 | 33 | 55 | 71 | 67 | 58 | 109 | 50 | 49 | 87 | 65 | 110 | 107 | 117 | 50 | 97 | 103 | 83 | 98 | 49 | 88 | 136 | 110 |
| Nuclear Periphery | 0 | 0 | 0 | 0 | 0 | 0 | 1 | 0 | 0 | 1 | 0 | 1 | 0 | 0 | 0 | 0 | 0 | 0 | 0 | 0 | 0 | 0 | 2 | 1 |
| Nucleolus | 4 | 1 | 1 | 2 | 1 | 1 | 1 | 1 | 2 | 3 | 2 | 1 | 4 | 2 | 2 | 11 | 12 | 22 | 0 | 1 | 1 | 0 | 1 | 1 |
| Peroxisomes | 0 | 0 | 0 | 0 | 0 | 0 | 0 | 0 | 0 | 0 | 0 | 0 | 0 | 1 | 1 | 0 | 0 | 0 | 0 | 0 | 0 | 0 | 0 | 0 |
| SpindlePole | 7 | 3 | 10 | 25 | 30 | 15 | 17 | 20 | 5 | 12 | 2 | 11 | 14 | 47 | 30 | 21 | 11 | 17 | 20 | 14 | 21 | 9 | 20 | 31 |
| Vac/Vac Membrane | 35 | 63 | 6 | 10 | 33 | 23 | 20 | 20 | 13 | 20 | 14 | 16 | 15 | 47 | 38 | 26 | 30 | 39 | 45 | 39 | 39 | 82 | 142 | 151 |
| Unique Cell Count | 164 | 159 | 98 | 134 | 210 | 236 | 287 | 350 | 223 | 231 | 312 | 236 | 263 | 392 | 433 | 130 | 176 | 192 | 211 | 193 | 158 | 270 | 498 | 493 |
| Labelled Cell Count | 214 | 183 | 102 | 156 | 239 | 290 | 362 | 445 | 292 | 299 | 417 | 314 | 285 | 428 | 467 | 170 | 210 | 245 | 211 | 193 | 158 | 270 | 498 | 493 |
Yeast GFP Assignment
Protein Abundance
| Screen | WT1 | WT2 | WT3 | RAP60 | RAP140 | RAP220 | RAP300 | RAP380 | RAP460 | RAP540 | RAP620 | RAP700 | HU80 | HU120 | HU160 | rpd3Δ_1 | rpd3Δ_2 | rpd3Δ_3 | AF100 | AF140 | AF180 |
|---|---|---|---|---|---|---|---|---|---|---|---|---|---|---|---|---|---|---|---|---|---|
| Mean Cell GFP Intensity (1e-4) | 3.7 | 5.0 | 5.2 | 5.1 | 4.8 | 3.9 | 3.6 | 4.1 | 3.8 | 3.8 | 3.2 | 3.7 | 4.8 | 5.4 | 5.3 | 5.8 | 6.6 | 6.4 | 4.9 | 5.3 | 5.5 |
| Std Deviation (1e-4) | 0.9 | 1.3 | 1.6 | 2.5 | 1.3 | 1.6 | 1.3 | 1.5 | 2.8 | 1.8 | 0.7 | 0.8 | 1.1 | 1.4 | 1.3 | 1.5 | 1.8 | 1.5 | 1.7 | 1.8 | 2.1 |
| Intensity Change (Log2) | – | – | – | -0.03 | -0.11 | -0.43 | -0.52 | -0.33 | -0.45 | -0.44 | -0.71 | -0.49 | -0.11 | 0.05 | 0.04 | 0.18 | 0.36 | 0.3 | -0.09 | 0.04 | 0.1 |
Localization Change
| Localization | RAP60 | RAP140 | RAP220 | RAP300 | RAP380 | RAP460 | RAP540 | RAP620 | RAP700 | HU80 | HU120 | HU160 | rpd3Δ_1 | rpd3Δ_2 | rpd3Δ_3 |
|---|---|---|---|---|---|---|---|---|---|---|---|---|---|---|---|
| Cortical Patches | 0 | 0 | 0 | 0 | 0 | 0 | 0 | 0 | 0 | 0 | 0 | 0 | 0 | 0 | 0 |
| Bud | 0 | 0 | 0 | 0 | 0 | 0 | 0 | 0 | 0 | 0 | 0 | 0 | 0 | 0 | 0 |
| Bud Neck | 0 | 0 | 0 | 0 | 0 | 0 | 0 | 0 | 0 | 0 | 0 | 0 | 0 | 0 | 0 |
| Bud Site | 0 | 0 | 0 | 0 | 0 | 0 | 0 | 0 | 0 | 0 | 0 | 0 | 0 | 0 | 0 |
| Cell Periphery | 0 | 0 | 0 | 0 | 0 | 0 | 0 | 0 | 0 | 0 | 0 | 0 | 0 | 0 | 0 |
| Cytoplasm | -1.3 | -1.8 | -1.2 | -1.7 | -1.7 | -2.5 | -1.5 | -4.0 | -2.1 | 0.2 | 0.5 | 2.0 | -3.6 | -4.2 | -5.8 |
| Endoplasmic Reticulum | 0 | 0 | 0 | 0 | 0 | 0 | 0 | 0 | 0 | 0 | 0 | 0 | 0 | 0 | 0 |
| Endosome | 0 | 0 | 0 | 0 | 0 | 0 | 0 | 0 | 0 | 0 | 1.8 | 1.6 | 1.9 | 1.9 | 2.3 |
| Golgi | 0 | 0 | 0 | 0 | 0 | 0 | 0 | 0 | 0 | 0 | 0 | 0 | 0 | 0 | 0 |
| Mitochondria | 1.4 | 0 | 0 | 0 | 0 | 0 | 0 | 0 | 0 | 0 | 0 | 0 | 1.9 | 0 | 0 |
| Nucleus | 1.1 | 0 | -1.0 | -2.7 | -0.5 | -2.1 | -2.4 | -1.1 | -1.1 | 1.4 | -1.2 | -1.3 | 0.7 | 3.4 | 3.2 |
| Nuclear Periphery | 0 | 0 | 0 | 0 | 0 | 0 | 0 | 0 | 0 | 0 | 0 | 0 | 0 | 0 | 0 |
| Nucleolus | 0 | 0 | 0 | 0 | 0 | 0 | 0 | 0 | 0 | 0 | 0 | 0 | 2.5 | 0 | 3.1 |
| Peroxisomes | 0 | 0 | 0 | 0 | 0 | 0 | 0 | 0 | 0 | 0 | 0 | 0 | 0 | 0 | 0 |
| SpindlePole | 1.8 | 0 | 0 | 0 | 0 | 0 | 0 | 0 | 0 | 0 | 0.5 | -1.1 | 1.3 | -1.2 | -0.4 |
| Vacuole | 0.4 | 2.4 | 1.1 | 0.3 | -0.2 | -0.1 | 0.8 | 0 | 0.2 | -0.2 | 1.7 | 0.9 | 3.0 | 2.6 | 3.2 |
External localization resources
Images






























Protein Concentration and Protein Localization Data
| R1 | R2 | R3 | ||||||||||||||||
|---|---|---|---|---|---|---|---|---|---|---|---|---|---|---|---|---|---|---|
| G1 Pre-START | G1 Post-START | S/G2 | Metaphase | Anaphase | Telophase | G1 Pre-START | G1 Post-START | S/G2 | Metaphase | Anaphase | Telophase | G1 Pre-START | G1 Post-START | S/G2 | Metaphase | Anaphase | Telophase | |
| Concentration | -0.7603 | -0.1122 | -0.6005 | 0.0914 | -1.1146 | -0.4811 | 0.5561 | 0.2925 | 0.4045 | -0.2154 | 0.2849 | 0.2239 | -0.4436 | -0.1832 | -0.1464 | -0.2255 | -0.1178 | -0.2317 |
| Actin | 0.0045 | 0.0002 | 0.0005 | 0.0006 | 0.0001 | 0.0002 | 0.0279 | 0.001 | 0.0142 | 0.0006 | 0.0089 | 0.0018 | 0.0105 | 0.0001 | 0.0001 | 0.0001 | 0.0018 | 0.0031 |
| Bud | 0.0003 | 0.0018 | 0 | 0.0001 | 0 | 0.0018 | 0.0008 | 0.0003 | 0.0014 | 0 | 0.0001 | 0.0002 | 0.0002 | 0.0001 | 0 | 0.0001 | 0 | 0.0001 |
| Bud Neck | 0.0017 | 0.0006 | 0.0009 | 0.0006 | 0.0006 | 0.0022 | 0.0052 | 0.0011 | 0.0015 | 0.0004 | 0.0006 | 0.0027 | 0.0019 | 0.0006 | 0.0007 | 0.0003 | 0.0005 | 0.0028 |
| Bud Periphery | 0.0003 | 0.0003 | 0 | 0 | 0 | 0.0005 | 0.0015 | 0.0003 | 0.0014 | 0 | 0.0005 | 0.0006 | 0.0002 | 0 | 0 | 0.0001 | 0.0001 | 0.0001 |
| Bud Site | 0.0019 | 0.0017 | 0.0002 | 0.0001 | 0 | 0.0001 | 0.0051 | 0.0023 | 0.0093 | 0 | 0.0001 | 0.0003 | 0.0006 | 0.0007 | 0.0003 | 0.0001 | 0.0002 | 0.0001 |
| Cell Periphery | 0.0001 | 0 | 0 | 0 | 0 | 0 | 0.0005 | 0.0001 | 0.0001 | 0 | 0.0001 | 0 | 0.0001 | 0 | 0 | 0 | 0 | 0 |
| Cytoplasm | 0.0578 | 0.0705 | 0.0253 | 0.0205 | 0.0329 | 0.0414 | 0.0587 | 0.0772 | 0.0353 | 0.0071 | 0.0465 | 0.0287 | 0.0744 | 0.0687 | 0.0262 | 0.0294 | 0.0251 | 0.0281 |
| Cytoplasmic Foci | 0.0085 | 0.0026 | 0.0042 | 0.0009 | 0.0008 | 0.0046 | 0.0225 | 0.0091 | 0.0098 | 0.0001 | 0.0038 | 0.0053 | 0.007 | 0.0065 | 0.0035 | 0.0007 | 0.0025 | 0.0013 |
| Eisosomes | 0.0002 | 0 | 0 | 0 | 0 | 0 | 0.0003 | 0 | 0.0002 | 0 | 0.0004 | 0 | 0.0001 | 0 | 0 | 0 | 0.0002 | 0.0001 |
| Endoplasmic Reticulum | 0.0021 | 0.0019 | 0.0005 | 0.0015 | 0.0003 | 0.0007 | 0.0056 | 0.0017 | 0.0026 | 0.0005 | 0.0014 | 0.0011 | 0.0028 | 0.0018 | 0.0006 | 0.0005 | 0.0008 | 0.0009 |
| Endosome | 0.0073 | 0.0031 | 0.0021 | 0.0025 | 0.0007 | 0.0025 | 0.0371 | 0.0047 | 0.0158 | 0.0007 | 0.0048 | 0.0051 | 0.0082 | 0.0025 | 0.0011 | 0.0008 | 0.0055 | 0.0022 |
| Golgi | 0.0012 | 0.0001 | 0.0004 | 0.0001 | 0 | 0.0001 | 0.0107 | 0.0003 | 0.0047 | 0 | 0.0087 | 0.0008 | 0.0014 | 0.0001 | 0.0001 | 0 | 0.0006 | 0.0004 |
| Lipid Particles | 0.005 | 0.0003 | 0.001 | 0.0001 | 0.0001 | 0.0003 | 0.0259 | 0.001 | 0.0036 | 0 | 0.0031 | 0.0036 | 0.0047 | 0.0004 | 0.0004 | 0 | 0.0035 | 0.0007 |
| Mitochondria | 0.0012 | 0.0007 | 0.0048 | 0.0009 | 0.0003 | 0.0004 | 0.0127 | 0.0014 | 0.0071 | 0.0015 | 0.0702 | 0.0041 | 0.0011 | 0.0004 | 0.0002 | 0.0004 | 0.0011 | 0.0006 |
| None | 0.15 | 0.1491 | 0.0997 | 0.1402 | 0.0844 | 0.0866 | 0.1216 | 0.1444 | 0.0528 | 0.0112 | 0.0784 | 0.0728 | 0.1137 | 0.1019 | 0.071 | 0.0128 | 0.0489 | 0.051 |
| Nuclear Periphery | 0.0233 | 0.0248 | 0.0198 | 0.0247 | 0.0176 | 0.012 | 0.0156 | 0.011 | 0.0123 | 0.0298 | 0.0157 | 0.0229 | 0.0188 | 0.013 | 0.0082 | 0.0095 | 0.0153 | 0.0184 |
| Nucleolus | 0.0131 | 0.0156 | 0.0145 | 0.0057 | 0.0088 | 0.0146 | 0.0173 | 0.0189 | 0.0227 | 0.006 | 0.006 | 0.0188 | 0.0127 | 0.0136 | 0.0112 | 0.0046 | 0.0102 | 0.0126 |
| Nucleus | 0.5487 | 0.6069 | 0.5797 | 0.7275 | 0.7544 | 0.6791 | 0.5367 | 0.5726 | 0.5848 | 0.9125 | 0.6288 | 0.7287 | 0.6192 | 0.6517 | 0.7008 | 0.8913 | 0.7791 | 0.7505 |
| Peroxisomes | 0.0028 | 0.0001 | 0.0013 | 0.0001 | 0 | 0.0001 | 0.0168 | 0.0003 | 0.0022 | 0.0001 | 0.0006 | 0.0046 | 0.0053 | 0.0001 | 0.0001 | 0 | 0.0006 | 0.0001 |
| Punctate Nuclear | 0.168 | 0.1168 | 0.2445 | 0.0726 | 0.0985 | 0.1519 | 0.0706 | 0.15 | 0.2155 | 0.0288 | 0.1193 | 0.0962 | 0.1144 | 0.1365 | 0.1747 | 0.0489 | 0.1028 | 0.1263 |
| Vacuole | 0.0013 | 0.0024 | 0.0004 | 0.0007 | 0.0003 | 0.0007 | 0.0051 | 0.0019 | 0.0017 | 0.0002 | 0.0007 | 0.0009 | 0.0022 | 0.001 | 0.0005 | 0.0003 | 0.0006 | 0.0005 |
| Vacuole Periphery | 0.0005 | 0.0005 | 0.0002 | 0.0006 | 0.0001 | 0.0002 | 0.0016 | 0.0004 | 0.001 | 0.0004 | 0.0013 | 0.001 | 0.0006 | 0.0002 | 0.0002 | 0.0002 | 0.0005 | 0.0004 |
Sequencing Data
| R1 | R2 | |||||||||
|---|---|---|---|---|---|---|---|---|---|---|
| G1 Post-START | S/G2 | Metaphase | Anaphase | Telophase | G1 Post-START | S/G2 | Metaphase | Anaphase | Telophase | |
| Gene Expression | 22.5843 | 13.4593 | 17.8346 | 17.9711 | 20.9154 | 22.5718 | 19.441 | 23.6185 | 16.4382 | 24.2998 |
| Translational Efficiency | 0.6742 | 0.4819 | 0.1179 | 0.2659 | 0.5585 | 0.6359 | 0.2328 | 0.1695 | 0.2878 | 0.4849 |
Hit Data
| Dataset | Hit |
|---|---|
| Protein Concentration | ✘ |
| Protein Localization | ✔ |
| Gene Expression | ✘ |
| Translational Efficiency | ✔ |
Endocytosis
| Temp | Actin Patch (Sac6-tdTomato) | Cortical Patch (Sla1-GFP) | Late Endosome (Snf7-GFP) | Vacuole (Vph1-GFP) |
|---|---|---|---|---|
| 37℃ | ||||
| RT |
Cell Cycle Omics
CYCLoPs (Bub3-GFP)
| Gene / Allele | Actin Patch (Sac6-tdTomato) | Cortical Patch (Sla1-GFP) | Late Endosome (Snf7-GFP) | Vacuole (Sac6-tdTomato) |
|---|
| Gene | Images |
|---|
| Gene | Images |
|---|
Images are not yet available
Images are not yet available